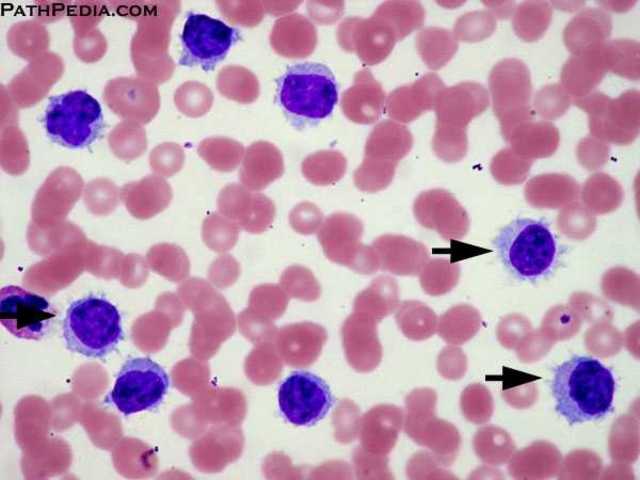
Leukemia Survival Rate at 57%

-
-
-
-
-
-
http://www.teamintraining.org/wch/Bruce Cleland and the Westchester/ Hudson Valley Chapter's first marathon
-
-
-
-
A list shows items. A timeline shows sequence.
Use Timetoast to make dates, milestones, and turning points easier to understand in a clear visual format. Timetoast is a timeline maker for work, school, research, and stories.